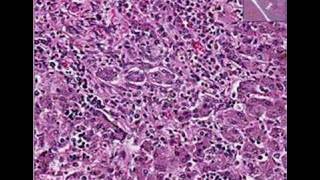

Histopathology Liver Cryptococcosis video
Online izle ve mp4 mp3 formatlarinda yukle

Videonun muddeti: 2:06
Histopathology Liver Cryptococcosis videosu mp4 ve mp3 yuklemek ucun hazirdir
Diqqet! Siz Mp4 yukle ve ya Mp3 yukle duymesine basdiqdan sonra eger sistem sizi reklam sehifesine atarsa o zaman derhal geri qayidib emeliyyati tekrar edin ve faylin yuklemek ucun hazir olmasini gozleyin
Videodan Mp4 Yukle
Videodan Mp3 Yukle-1
Videodan Mp3 Yukle-2
Oxshar Axtarishlar
 Histopathology Liver --Cryptococcosis
Histopathology Liver --Cryptococcosis Cryptococcus neoformans infection - symptoms, pathophysiology, diagnosis, treatment
Cryptococcus neoformans infection - symptoms, pathophysiology, diagnosis, treatment Histopathology Liver--Viral hepatitis with fulminant necrosi
Histopathology Liver--Viral hepatitis with fulminant necrosi Histopathology Liver--Alcoholic liver disease
Histopathology Liver--Alcoholic liver disease Histopathology Liver--Hemochromatosis
Histopathology Liver--Hemochromatosis Histopathology Liver--Hepatitis, yellow fever virus
Histopathology Liver--Hepatitis, yellow fever virus Histopathology Liver--Congenital cytomegalovirus disease
Histopathology Liver--Congenital cytomegalovirus disease Histopathology Liver --Histoplasmosis
Histopathology Liver --Histoplasmosis Histopathology Liver--Acute and chronic cholangitis
Histopathology Liver--Acute and chronic cholangitis
Video Mp4 Mp3Azwap.Biz
Azwap.Biz 2021-2023


 Histopathology Liver --Cryptococcosis
Histopathology Liver --Cryptococcosis Cryptococcus neoformans infection - symptoms, pathophysiology, diagnosis, treatment
Cryptococcus neoformans infection - symptoms, pathophysiology, diagnosis, treatment Histopathology Liver--Viral hepatitis with fulminant necrosi
Histopathology Liver--Viral hepatitis with fulminant necrosi Histopathology Liver--Alcoholic liver disease
Histopathology Liver--Alcoholic liver disease Histopathology Liver--Hemochromatosis
Histopathology Liver--Hemochromatosis Histopathology Liver--Hepatitis, yellow fever virus
Histopathology Liver--Hepatitis, yellow fever virus Histopathology Liver--Congenital cytomegalovirus disease
Histopathology Liver--Congenital cytomegalovirus disease Histopathology Liver --Histoplasmosis
Histopathology Liver --Histoplasmosis Histopathology Liver--Acute and chronic cholangitis
Histopathology Liver--Acute and chronic cholangitis